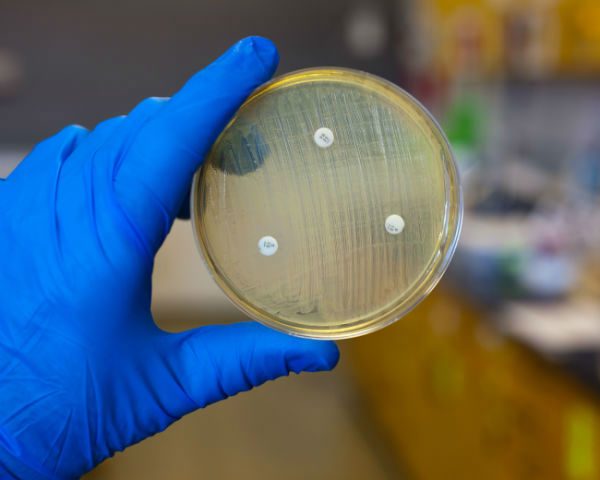

ميونيخ/مدريد 19 تشرين أول/أكتوبر 2014 (د ب أ)- أعرب أخصائي الأمراض المعدية الألماني برنهارد روف عن رأيه في أن هناك نقص في الإجراءات الوقائية المتبعة أثناء علاج مرضى إيبولا في إسبانيا والولايات المتحدة الأمريكية.
وكتب الطبيب الألماني في بريد القراء بمجلة "فوكوس" الألمانية أنه خطأ فادح أن يرتدي الأطباء والممرضين السترات الوقائية بأنفسهم في المستشفى بمدريد.
وأضاف روف أن هذا الأمر لا يحدث في المستشفى التي يعمل بها في لايبتسيج، موضحا أنه يتم تخصيص شخص لمراقبة الآخرين أثناء تبديل السترات ليكتشف أية أخطاء تحدث أثناء ذلك.
يذكر أن ممرضة بمستشفى كارلوس الثالث أصيبت بعدوى فيروس إيبولا أثناء علاج مريض هناك. ولم يتم الكشف بشكل رسمي عن سبب انتقال العدوى إليها. ومن المحتمل أن تكون حدثت هذه العدوى أثناء خلع سترتها الوقاية.
جدير بالذكر أن هذه الممرضة تتعافي الآن.
وهناك ممرضتان أصيبتا بعدوى الإيبولا أثناء رعاية مريض مصاب بالفيروس في الولايات المتحدة الأمريكية.
وأضاف الطبيب الألماني أنه من الممكن أن يتراجع عدد المصابين بإيبولا في العام القادم "عن طريق المساعدات الأفضل تنظيما من الخارج وربما عن طريق التطعيم (…) وكذلك عن طريق تطوير أجسام مضادة أخرى لعلاج الفيروس".
وإلى أن يتم تحقيق ذلك يتوقع روف انتشار فيروس إيبولا خارج قارة أفريقيا.